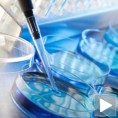
Вантелесна оплодња за више парова

Друштво
понедељак, 19. авг 2013, 20:03 -> 21:52
Делови Београда без уличне расвете
Због квара трафо станице на Новом Београду, велики делови Новог Београда, Старог града и Чукарице су без јавне расвете која се није аутоматски укључила...
понедељак, 19. авг 2013, 18:07 -> 18:18
Преминуо новинар Ђорђе Зоркић
Новинар и један од оснивача Новинске агенције Бета Ђорђе Зоркић преминуо је прошле ноћи у Београду у 74. години...
понедељак, 19. авг 2013, 15:31 -> 15:51
Вељовић: Контрола не подразумева "кидање глава"
У оквиру реформе Министарства унутрашњих послова Србије, сигурно ће бити одређених промена, нарочито када је реч о припремама за улазак земље у ЕУ, каже Милорад Вељовић. Сама та контрола не подразумева...
понедељак, 19. авг 2013, 14:29 -> 14:58
Решење за наставнике без пуног фондa?
Синдикат образовања Србије тражи да наставници који су остали без пуног фонда часова преузму вишак часова својих колега из школа које су уписале већи број ученика од планираног...
понедељак, 19. авг 2013, 12:07 -> 20:08
Сећање на јунаке са Цера
На Церу одата почаст учесницима једне од најзначајнијих битака српске војске у Првом светском рату, која је окончана на данашњи дан, пре 99 година. Сећањем на храбре претке славимо живот и мир, поручио...
понедељак, 19. авг 2013, 11:00 -> 11:21
Вирус Западног Нила усмртио четири особе
Четири особе умрле од грознице Западног Нила у Србији, а забележено је укупно 63 случаја обољевања. Умрле особе биле старије од 50 година и биле су хронични болесници...
понедељак, 19. авг 2013, 10:36 -> 11:15
Вантелесна оплодња за више парова
Ускоро би требало да буду проширени капацитети Клинике за гинекологију и акушерство, што ће омогућити много више процедура вантелесне оплодње, поручио директор Клинике Александар Стефановић у Дневнику...
понедељак, 19. авг 2013, 08:51 -> 10:17
Аранжмани за Египат до средине октобра
Док наши туристи упркос ванредном стању у Египту и даље одлазе на летовање у ту земљу Словенци су вратили своје турист. Туристичке агенције имају у понуди аранжмане за Египат до средине октобра...
понедељак, 19. авг 2013, 07:30 -> 11:54
Годишњица Церске битке
Полагањем венаца и уз државне и војне почасти обележава се 99. годишњица прве победе над централним силама у Првом светском рату. Централну државну церемонију предводи премијер Србије Ивица Дачић...
понедељак, 19. авг 2013, 07:30 -> 16:43
Времеплов (19. август 2013)
Међународни дан хуманитарних радника. Национални празник Авганистана. Преображење Господње (по Јулијанском календару)...

Коментари